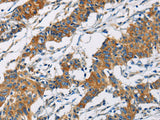
PIP4K2A Polyclonal Antibody Store at -20°C

PIP4K2A Polyclonal Antibody Store at -20°C
SKU: E-AB-10953-200
PIP4K2A Polyclonal Antibody Store at -20°C
| SKU # | E-AB-10953 |
| Reactivity | Human, Mouse, Rat |
| Host | Rabbit |
| Applications | WB, IHC |
Product Details
| Isotype | IgG |
| Host | Rabbit |
| Reactivity | Human, Mouse, Rat |
| Applications | WB, IHC |
| Clonality | Polyclonal |
| Immunogen | Recombinant protein of human PIP4K2A |
| Abbre | PIP4K2A |
| Synonyms | 1 phosphatidylinositol 4 phosphate 5 kinase, 1 phosphatidylinositol 4 phosphate 5 kinase 2 alpha, 1 phosphatidylinositol 4 phosphate kinase, 1-phosphatidylinositol-5-phosphate 4-kinase 2-alpha, 4 5 kinase B isoform, 4 5 kinase C isoform, 4 5 kinase isoform 2 al |
| Swissprot | |
| Calculated MW | 46 kDa |
| Cellular Localization | Cytosol, Nucleus, nucleoplasm, Plasma Membrane, Other locations: autophagosome. |
| Concentration | 0.3 mg/mL |
| Buffer | Phosphate buffered solution, pH 7.4, containing 0.05% stabilizer and 50% glycerol. |
| Purification Method | Affinity purification |
| Research Areas | Cancer, Metabolism, Signal Transduction |
| Conjugation | Unconjugated |
| Storage | Store at -20°C Valid for 12 months. Avoid freeze / thaw cycles. |
| Shipping | The product is shipped with ice pack,upon receipt,store it immediately at the temperature recommended. |
Related Reagents
| Applications | Recommended Dilution |
| WB | 1:500-1:2000 |
| IHC | 1:50-1:200 |
Background
Phosphatidylinositol-5,4-bisphosphate, the precursor to second messengers of the phosphoinositide signal transduction pathways, is thought to be involved in the regulation of secretion, cell proliferation, differentiation, and motility. The protein encoded by this gene is one of a family of enzymes capable of catalyzing the phosphorylation of phosphatidylinositol-5-phosphate on the fourth hydroxyl of the myo-inositol ring to form phosphatidylinositol-5,4-bisphosphate. The amino acid sequence of this enzyme does not show homology to other kinases, but the recombinant protein does exhibit kinase activity. This gene is a member of the phosphatidylinositol-5-phosphate 4-kinase family.